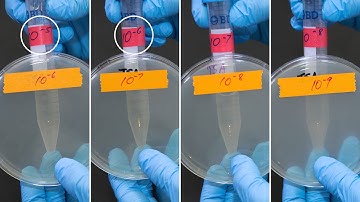
MCB2010C Lab: Serial Dilution and Plate Count

⬇ DOWNLOAD NOW
Jika muncul iklan pop-up, tutup lalu klik tombol kembali
Download lagu Serial Dilution and Plate Counts secara gratis hanya untuk keperluan promosi. Dukung artis favorit kamu dengan membeli musik original di iTunes atau platform resmi lainnya.
 Serial Dilutions | Microbiology
Serial Dilutions | Microbiology How to prepare a Serial Dilution
How to prepare a Serial Dilution How to Perform Serial Dilutions in Microbiology
How to Perform Serial Dilutions in Microbiology Serial dilution and plate count
Serial dilution and plate count MCB2010C Lab: Serial Dilution and Plate Count
MCB2010C Lab: Serial Dilution and Plate Count Serial Dilutions
Serial Dilutions Standard plate count
Standard plate count Pharmaceutical Microbiology Lab - Serial dilution and bacterial counting
Pharmaceutical Microbiology Lab - Serial dilution and bacterial counting